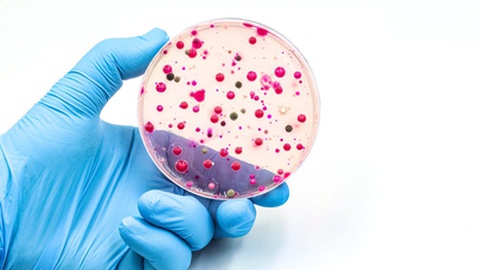
None
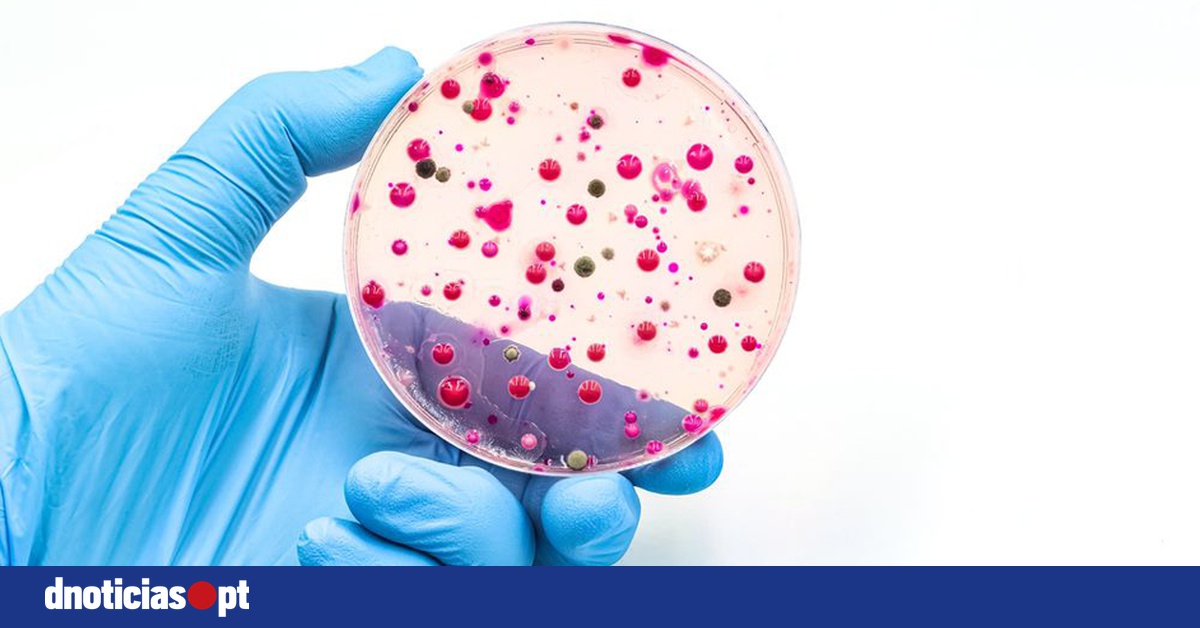
DNOTICIAS.PT

Estudo revela novos factores que explicam a virulência de bactéria multirresistente
Equipa de cientistas é liderada pela Universidade de Coimbra
Uma equipa de cientistas, liderada pelo Centro de Neurociências e Biologia Celular da Universidade de Coimbra (CNC-UC), integrado no Centro de Inovação em Biomedicina e Biotecnologia (CiBB), identificou um novo conjunto de fatores que ajudam a explicar a virulência elevada da bactéria multirresistente Staphylococcus aureus. Estes novos dados abrem caminho ao desenvolvimento de terapias inovadoras, capazes de eliminar esta população de bactérias, contribuindo, assim, para combater infeções crónicas e recorrentes.
Este estudo, publicado na revista Nature Communications, fornece novas pistas sobre como a bactéria se esconde, sobrevive e se multiplica dentro dos fagócitos não profissionais, células humanas cuja primeira função não é a defesa imunitária e nas quais alguns antibióticos demonstram menor eficácia.
O Staphylococcus aureus é um patógeno que constitui uma das principais causas de doença hospitalar e comunitária. As infeções causadas por estirpes de Staphylococcus aureus resistentes à meticilina (ou MRSA) constituem a segunda causa mais comum de morte associada à resistência bacteriana a antibióticos. Atualmente, esta bactéria é responsável por mais de um milhão de mortes por ano e uma das principais causas de doença hospitalar e comunitária.
Conduzido com recurso a ensaios de infeção por microscopia de fluorescência automatizada de larga escala, o estudo identifica um conjunto de fatores nunca antes associados à vida intracelular e virulência desta bactéria. Para a investigadora do CNC-UC e líder do estudo, Ana Eulálio, "compreender os mecanismos de infeção e adaptação intracelular da bactéria Staphylococcus aureus permitiu-nos desvendar como este microorganismo consegue escapar ao sistema imunitário e resistir aos antibióticos, expandindo assim o conhecimento recente sobre a sua biologia e virulência".
Os cientistas identificaram 73 genes que influenciam fortemente a capacidade de a Staphylococcus aureus invadir, persistir e se multiplicar no interior de células humanas, e até de causar a morte destas células. O estudo contemplou um total de 1920 mutantes da bactéria.
Destaca-se também a descoberta de uma nova função da enzima nicotinamidase (PncA), que regula o sistema de virulência da Staphylococcus aureus – o sistema agr (Accessory Gene Regulator), que determina a expressão de muitos fatores de virulência. Este trabalho demonstrou que a PncA controla a atividade do sistema agr através da regulação do metabolismo da bactéria.
A caracterização do papel da proteína PncA na virulência também abre novas perspetivas para a investigação do papel do metabolismo bacteriano na infeção. Estas descobertas oferecem múltiplos pontos de partida para explorar novos alvos terapêuticos e compreender melhor as interações entre bactéria e hospedeiro.
"Nos últimos anos, tem-se acumulado evidência de que a bactéria Staphylococcus aureus não é apenas um patógeno extracelular [que vive fora das células do hospedeiro], mas que, pelo contrário, consegue estabelecer-se dentro de células humanas, contribuindo para infeções persistentes", explica a investigadora.
De recordar que a investigação do grupo RNA & Infeção do CNC-UC, liderado por Ana Eulálio, sobre a sobrevivência intracelular e a resistência aos antibióticos da bactéria Staphylococcus aureus foi recentemente financiada pelo concurso de Investigação em Saúde de 2025 da Fundação 'la Caixa' com cerca de meio milhão de euros.
O estudo "Systematic identification of bacterial factors driving Staphylococcus aureus intracellular lifestyle in non-professional phagocytes" (Identificação sistemática dos fatores bacterianos que determinam o estilo de vida intracelular da Staphylococcus aureus em fagócitos não profissionais, em português) resulta de uma colaboração entre o CNC-UC e investigadores do Centro Nacional de Biotecnologia – Conselho Superior de Investigações Científicas de Espanha (National Centre for Biotechnology – Spanish National Research Council) e do Imperial College de Londres (Imperial College London).
O artigo científico está disponível neste link.